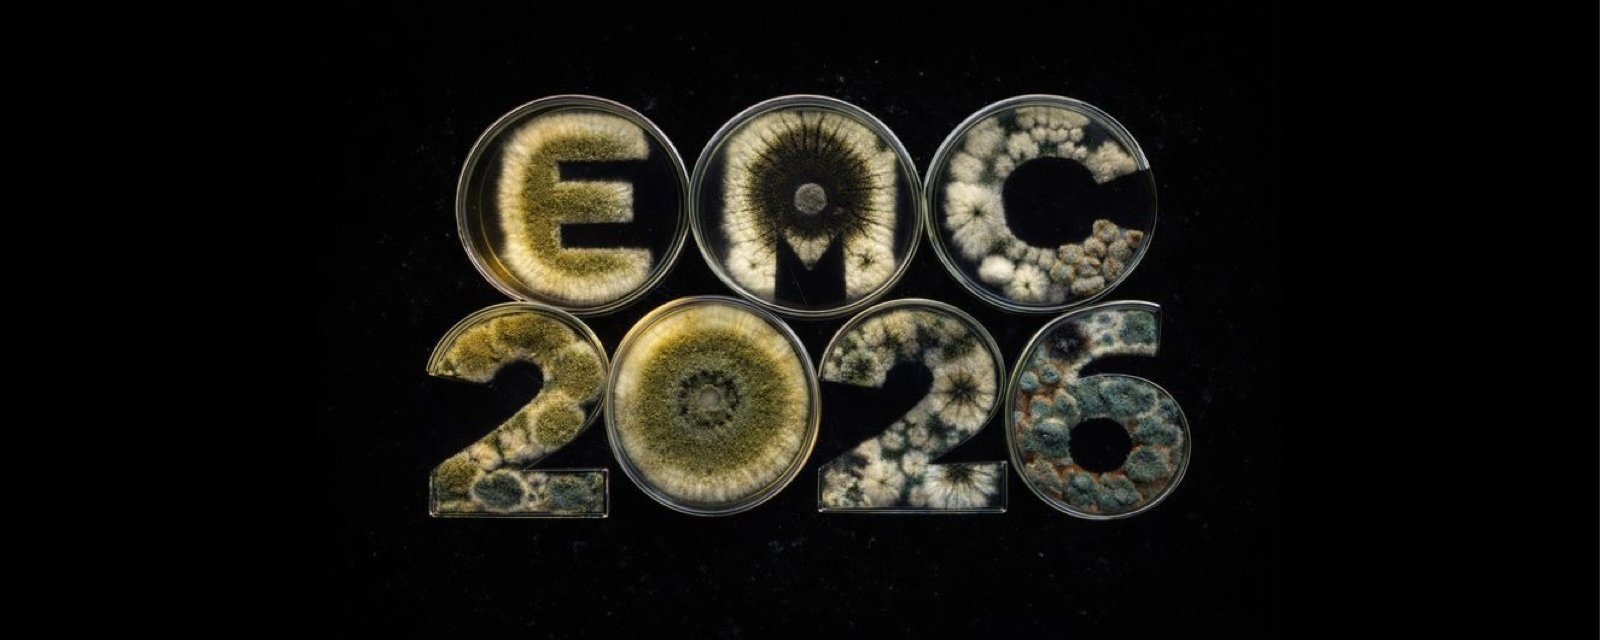
Slider

Our Congress Announced on the International Mycological Association(IMA) Website https://www.ima-mycology.org
INVITATION TO THE CONGRESS
Dear Colleagues,
We are pleased to announce that the 5th International Eurasian Mycology Congress (EMC 2026) will be held on 1–3 September 2026 in Edirne, Türkiye, and will be hosted by Trakya University.
The congress aims to bring together researchers, undergraduate and graduate students, and professionals from related sectors working in mycology, providing an international scientific platform for the exchange of knowledge and experience and for strengthening academic interaction and collaborative research.
The scientific program will encompass current and innovative studies across all major subdisciplines of mycology and will include oral and poster presentations, along with lectures by distinguished invited speakers. EMC 2026 is designed to provide a comprehensive, high-quality academic environment that promotes scientific discussion and interdisciplinary cooperation.
We are delighted to invite you to Edirne, a city of exceptional historical and cultural significance, located at the crossroads of civilizations and at the border of Greece and Bulgaria. We believe that the city’s rich cultural heritage, combined with its strategic location, will provide an inspiring setting for scientific exchange.
Your valuable scientific contributions and participation will greatly enhance the academic quality and international impact of the congress. We would be honored to welcome you to EMC 2026 and to share this important scientific gathering.
Kind regards,
On behalf of the Organizing Committee
KARABIYIK Halide, PhD
Chair of the Congress
5th International Eurasian Mycology Congress
Trakya University, Edirne, Türkiye